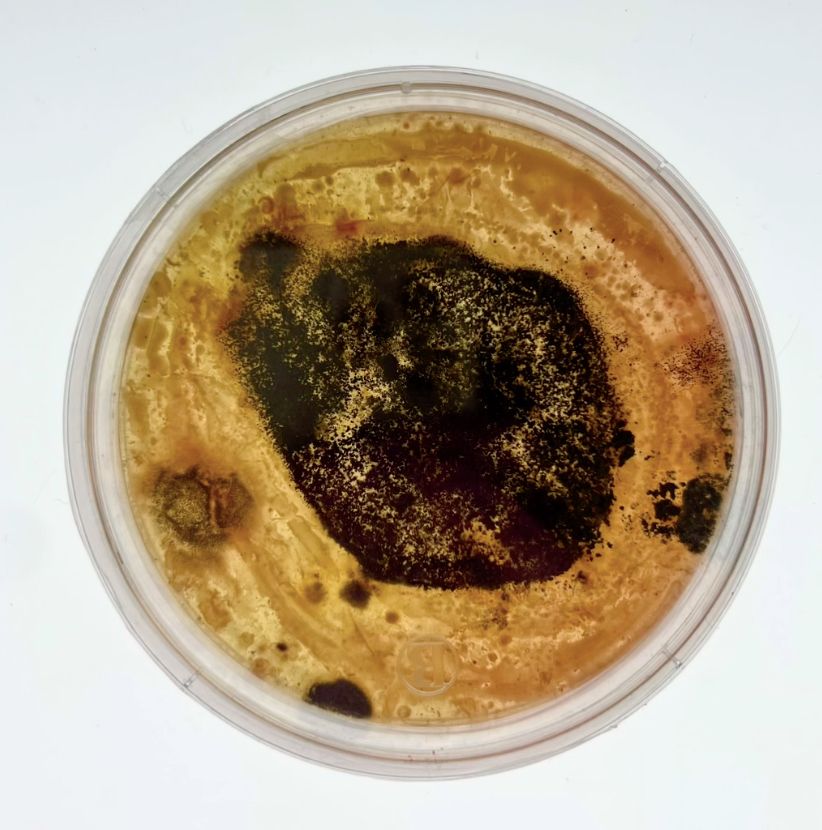
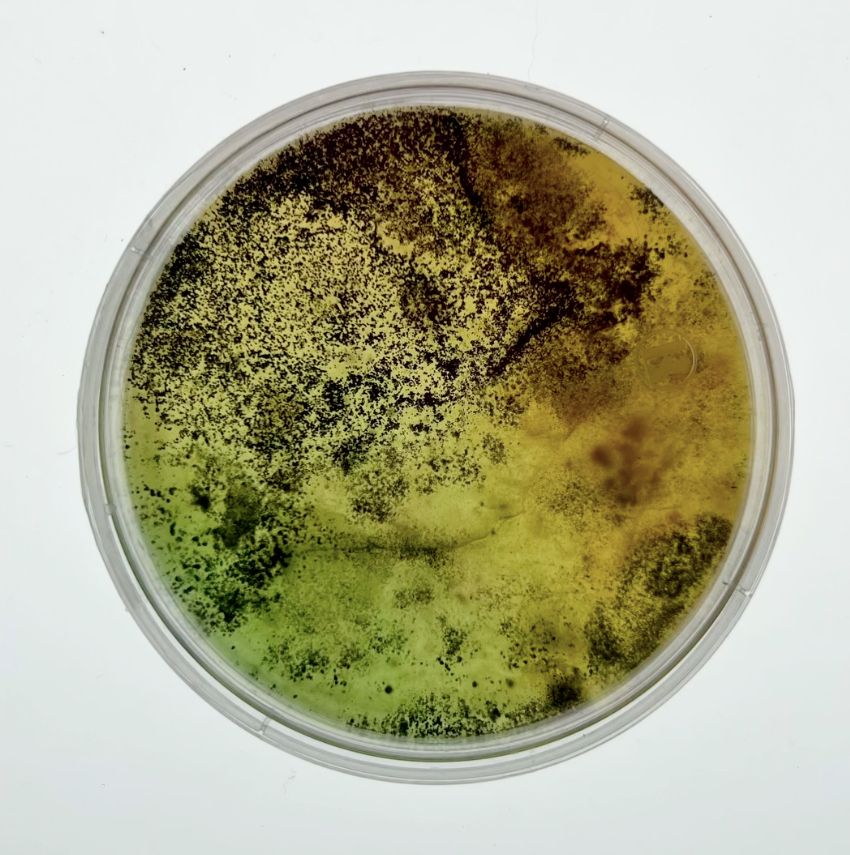

Sofiasleep
Sofía Valdivia es una artista visual ariqueña, titulada en Artes Visuales por la Universidad Andrés Bello. Actualmente vive en Santiago de Chile, en el Barrio Yungay. Su trabajo explora la intersección entre lo natural y lo inerte, utilizando el bioarte como una herramienta para cuestionar la percepción del cuerpo, la identidad y el entorno.
Desde la experimentación con procesos biológicos, desarrolla experiencias visuales que articulan el cruce entre arte y ciencia. A través del color, la textura y la materialidad viva, su práctica propone una aproximación estética y reflexiva, donde el proceso se vuelve parte fundamental de la construcción visual de la obra.